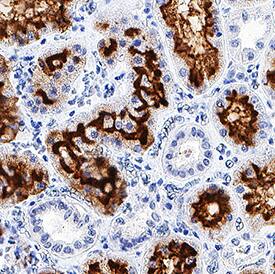
Neprilysin/CD10 antibody in Human Kidney by Immunohistochemistry (IHC-P).

Human Neprilysin/CD10 Antibody
R&D Systems, part of Bio-Techne | Catalog # MAB11822


Key Product Details
Species Reactivity
Applications
Label
Antibody Source
Product Specifications
Immunogen
Tyr52-Trp750
Accession # P08473
Specificity
Clonality
Host
Isotype
Scientific Data Images for Human Neprilysin/CD10 Antibody
Detection of Human Neprilysin/CD10 by Western Blot.
Western blot shows lysates of A172 human glioblastoma cell line and Ramos human Burkitt's lymphoma cell line. PVDF membrane was probed with 1 µg/mL of Mouse Anti-Human Neprilysin/CD10 Monoclonal Antibody (Catalog # MAB11822) followed by HRP-conjugated Anti-Mouse IgG Secondary Antibody (Catalog # HAF018). A specific band was detected for Neprilysin/CD10 at approximately 100 kDa (as indicated). This experiment was conducted under reducing conditions and using Immunoblot Buffer Group 1.Neprilysin/CD10 in Human Kidney.
Neprilysin/CD10 was detected in immersion fixed paraffin-embedded sections of human kidney using Mouse Anti-Human Neprilysin/CD10 Monoclonal Antibody (Catalog # MAB11822) at 0.5 µg/mL for 1 hour at room temperature followed by incubation with the Anti-Mouse IgG VisUCyte™ HRP Polymer Antibody (Catalog # VC001). Before incubation with the primary antibody, tissue was subjected to heat-induced epitope retrieval using Antigen Retrieval Reagent-Basic (Catalog # CTS013). Tissue was stained using DAB (brown) and counterstained with hematoxylin (blue). Specific staining was localized to cell surface in epithelial cells. View our protocol for IHC Staining with VisUCyte HRP Polymer Detection Reagents.Applications for Human Neprilysin/CD10 Antibody
Immunohistochemistry
Sample: Immersion fixed paraffin-embedded sections of human kidney tissue
Western Blot
Sample: A172 human glioblastoma cell line and Ramos human Burkitt's lymphoma cell line
Formulation, Preparation, and Storage
Purification
Reconstitution
Formulation
Shipping
Stability & Storage
- 12 months from date of receipt, -20 to -70 °C as supplied.
- 1 month, 2 to 8 °C under sterile conditions after reconstitution.
- 6 months, -20 to -70 °C under sterile conditions after reconstitution.
Background: Neprilysin/CD10
Neprilysin/CD10, also known as NEP and neutral endopeptidase 24.11, is a zinc metallopeptidase expressed at the cell surface of a variety of cells. The enzyme functions both as an endopeptidase with a thermolysin-like specificity and as a dipeptidylcarboxypeptidase. NEP has been shown to be involved in the degradation of enkephalins in the mammalian brain and the inactivation of circulating atrial natriuretic peptide (1, 2). NEP has also been identified as the common acute lymphocytic leukemia antigen (CALLA), and is expressed on the surface of lymphocytes in some disease states (3, 4). These and other observations have resulted in considerable interest in NEP as a target for analgesics and antihypertensive drugs. NEP is also a major degrading enzyme of amyloid beta peptide (A beta) in the brain, indicating that down-regulation of NEP activity, which could be caused by aging, can contribute to the development of Alzheimer’s disease by promoting A beta accumulation (5).
References
- Malfroy, B. et al. (1978) Nature 276:523.
- Kenny, A.J. and Stephenson, S.L. (1988) FEBS Lett. 232:1.
- LeTarte, M. et al. (1988) J. Exp. Med. 168:1247.
- Shipp, M.A. et al. (1988) Proc. Natl. Acad. Sci. USA 85:4819.
- Itwata, N. et al. (2001) Science 292:1550.
Alternate Names
Gene Symbol
UniProt
Additional Neprilysin/CD10 Products
Product Documents for Human Neprilysin/CD10 Antibody
Product Specific Notices for Human Neprilysin/CD10 Antibody
For research use only